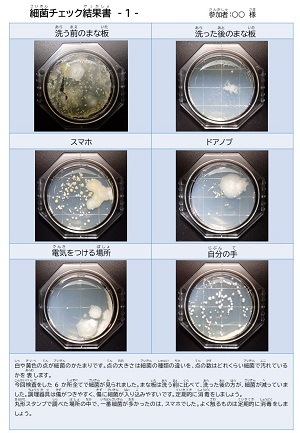
結果書１
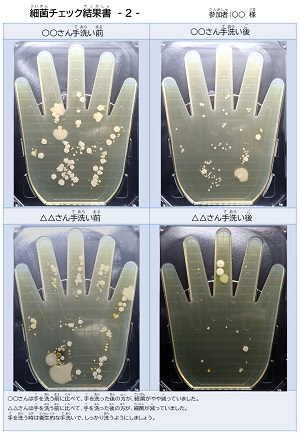
結果書２
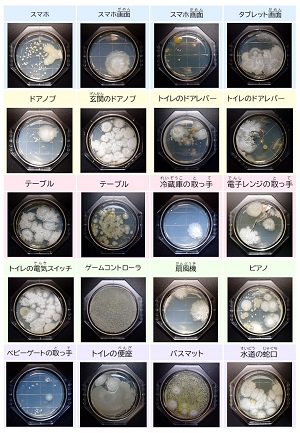
丸形スタンプ結果
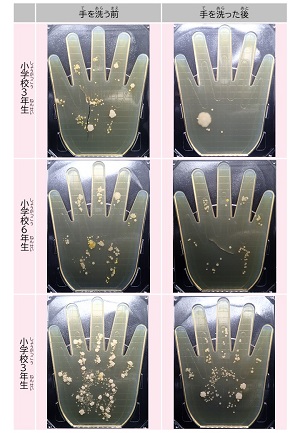
手洗い結果

【実施報告】
「令和5年度 みんなでつくろう手打ちそば(お家の衛生検査もできるよ)」
今年度の食の安全塾は、手洗いの大切さや食品衛生に関する知識に加え、くらしの衛生について学んでいただくことを目的として、食品衛生月間行事(そば打ち)に参加してくれた福岡市内在住の小学生と保護者の方を対象に実施しました。
そば打ちに参加してくれる福岡市内在住の小学生と保護者の方にテキストと細菌チェックキット、ダニ検査キットを郵送して、自宅の検査を行っていただきました。



参加者に家庭で気になる所に細菌チェックキットでぺったん検査してもらいました。

家の中の気になる場所のダニの量や、掃除の前後でどれくらい減るかなど調べたい場所で、掃除機を使って、専用の袋にごみを採取してもらいました。


自宅で検査した細菌チェックキットとダニ検査キットをそば打ちの日に持参してもらいました。
また、そば打ちの日に衛生的な手洗い方法を学んでもらい、手洗い前後の手指を手形細菌検査キットを使用してぺったん検査してもらいました。
細菌検査キットは、保健所で細菌を増やして、見えるようにしました。
検査結果を結果書にまとめ、ひとりひとりにお返ししました。
細菌チェック結果書の丸い点が細菌です。

参加者のみなさんがさまざまな場所を検査してくださいました!
手洗い前後の結果を共有しました!

ダニの検査では、採取してもらったごみの中のダニの量を保健所で検査して、結果をひとりひとりにお返ししました。






参加者からは
「洗浄後の調理器具の細菌が少ししか減っていないことに驚いた。」
「とても楽しかった。」
「きれいにしているつもりだったと証明された。」
といった声をいただきました。
参加者のみなさまありがとうございました。
食の安全とくらしの衛生をテーマにした食とくらしのリスクコミュニケーション事業は今後も開催予定です。
みなさまの参加をお待ちしています!



 東区
東区 博多区
博多区 中央区
中央区 南区
南区 城南区
城南区 早良区
早良区 西区
西区